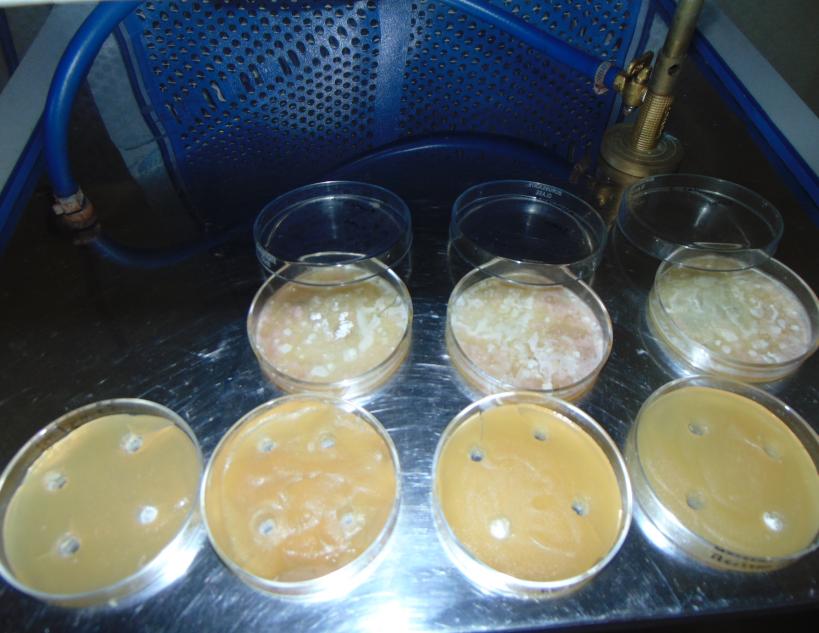
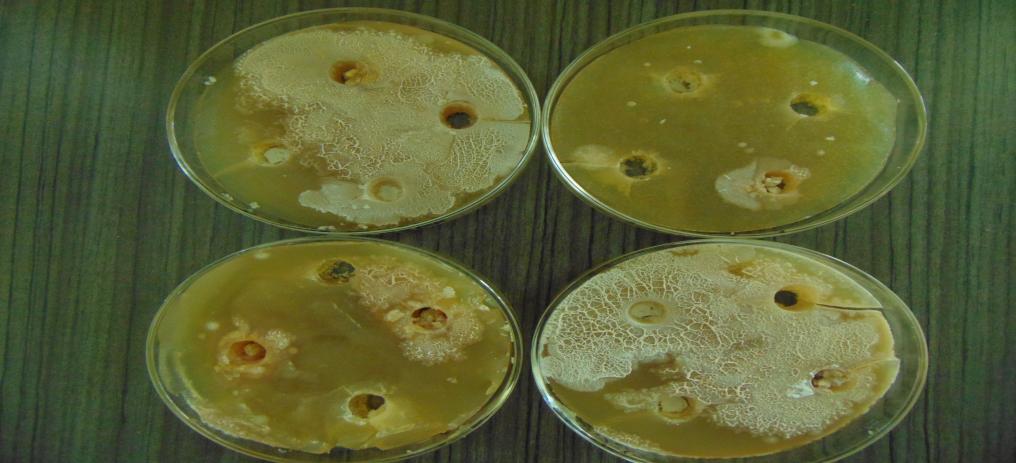

- Visibility 1.5k Views
- Downloads 593 Downloads
- Permissions
- DOI 10.18231/j.ijpca.2022.003
-
CrossMark
- Citation
Formulation development and evaluation of novel herbal toothpaste from natural source
- Author Details:
-
K.L. Senthilkumar *
-
S. Venkateswaran.
-
A. Vasanthan
-
P. Chiranjeevi
-
N Mohamed
-
S. Dinesh
-
K.L.S. Neshkumar.
Abstract
Herbal toothpaste with natural ingredients is more acceptable in public opinion than chemical-based synthetic formulations in the current oral dental care scenario due to their safety and efficacy in reducing dental caries and preventing other dental disorders to which this generation is prone. In this composition, we use aloe Vera gel, clove oil, Neem powder, pomegranate peel powder, all of which have never been used before in any research. These extracts have anti-ulcer, anti-caries, anti-bacterial, and wound-healing properties, as well as certain unique properties including anti-cancer and anti-fungal. Herbal toothpastes were evaluated to determine important physical characteristics such as pH, stability, extrudability, spreadability, foamability, and homogeneity in order to develop a more effective and stable product. The purpose of this project is to make and test herbal toothpaste. This research proves that our herbal-based toothpaste formulation with natural ingredients is as excellent as it gets in terms of performance.
Introduction
Herbal and herbal-based toothpaste has been used in ancient life for many years and is one of the most significant aspects of oral health care.[1] The manufacture and development of toothpaste formulations dates back to 300-500 BC in China and India. During that time, abrasives such as squashed bone, crumbled egg, and clam shells were used to clean teeth. In the nineteenth century, modern toothpaste compositions were created. Chalk and soap were added to those compositions after advancements in the realm of medicine. Following independence, multiple formulation developments of various detergents began, with sodium lauryl sulphate serving as an emulsifying agent.[2], [1], [3], [4], [5] The focus has switched in the current period to the release of active substances during formulation development in order to prevent and/or treat oral disease.[2], [1], [3] Toothpaste is a dentifrice that is used to keep teeth clean, maintain their health, and improve their appearance. Toothpaste is primarily used to maintain oral hygiene, but it also functions as an abrasive, removing dental plaque and food particles from the teeth, assisting in the removal and/or veiling of halitosis, and releasing active chemicals like fluoride to help prevent tooth and gum disease (Eg. Gingivitis). The majority of the cleaning is done by the toothbrush's mechanical action, with the help of excipients included in toothpaste.[6], [7], [8] Many herbal formulations are particularly successful because they contain active chemical components like polyphenols, gums, alkaloids, glycosides, and other compounds. Different biological functions have also been explored for these formulations. This expands the possibilities for developing and testing new herbal toothpaste formulations. The main goal is to make herbal toothpaste and evaluate it.
Ideal Properties of Toothpaste
Good abrasive effect
Non irritant and non-toxic
Impart no stain in tooth
Keep the mouth fresh and clean
Prolonged effect
Cheap and easily available
Remedies for tooth paste
The compound in ginger can even help reduce the oral bacteria that end up in cavities and to gum diseases making it a generally effective ally to your oral health.
Ginger can aid in the prevention of cavities and the removal of plaque.
Ginger can strengthen the gum tissues around your teeth.
Ginger may also prevent inflammation.
Ginger naturally has anti-inflammatory properties in it which helps you while feeling discomfort.
Material and Methods
One formulation of herbal toothpaste is prepared by using different ingredients like Calcium Carbonate as abrasive, Glycerin as humectant, Sodium Lauryl Sulphate as a detergent and foaming agent, Peppermint Oil as a flavoring ingredient, Sodium Benzoate as a preservative, and Sodium Saccharine as a sweetener. In addition, an anti-inflammatory substance derived from ginger oil is included. A method used for the formulation of herbal toothpaste is homogenization by using mortar and pestle for formation base of toothpaste.
Materials
The weight of each ingredient was determined based on the results of a previous study on the composition of herbal toothpaste. All of the ingredients in this toothpaste have a combined percentage by weight of 100%, which implies that the whole quantity of toothpaste will yield 100gm of tooth paste formulation.[9]
Method of formulation
There are two types of toothpaste formulation procedures, viz.
Dry gum method,
Wet gum method,
Dry gum method
Preparation of base
The solid ingredients calcium carbonate, sodium lauryl sulphate, glycerin, sodiumbenzoate, sodium saccharine were weighed accurately as mentioned in the formula and sieved with sieve no.80 so as to maintain the particle size.
These ingredients were also mixed in a mortar and pestle, then triturated with precisely weighed glycerin until a semisolid substance was created.
Addition of herbal ingredients-
Accurately weighed herbal extract in form of ginger oil were added to the base
At the end, peppermint oil was added as a flavor[10]
|
S.no |
Ingredients(gm) |
Quantity(w/w) % |
Uses |
|
1 |
Ginger oil(ACTIVE INGREDIENT) |
2ml |
Used as anti- inflammatory(in gingivitis) |
|
2 |
Sodium lauryl sulphate |
1.5gm |
Detergent & foaming agent |
|
3 |
Sodium benzoate |
0.1gm |
Used as preservative |
|
4 |
Sodium saccharine |
0.2gm |
Used as sweetening agent |
|
5 |
Glycerin |
40ml |
Used as humectant |
|
6 |
Calcium carbonate |
44gm |
Used as abrasive |
|
7 |
Pepper mint oil |
Qs |
Used as flavoring agent |
Evaluation of herbal toothpaste[9], [11], [12]
Physical examination (colour, odour, taste, smoothness, and relative density
The colour of the toothpaste was assessed visually. Smelling the product revealed the presence of odour. The taste of the formulation was tested manually. The smoothness of the paste formulation was verified by rubbing it between the fingers. As can be seen in fig. 1,

PH
To make a 50% aqueous suspension, pour 10 grams of toothpaste from the container into a 50 mL beaker and add 10 mL of freshly boiled and cooled water (at 270C). To ensure a complete suspension, stir thoroughly. Using a PH meter, determine the PH of the suspension in 5 minutes. As shown in fig. 2,

Homogeneity
By applying normal force at 27°C, the toothpaste should extrude a homogeneous mass from the collapsible tube or other suitable container. Furthermore, the bulk of the contents must extrude from the container's crimp and be rolled out gradually.
Sharp and edge abrasive particles
To verify for the presence of any sharp or abrasive particles, the contents were placed on the finger and scratched on the butter paper for 15-20cm. I went through the same process at least ten times. There were no sharp or edge abrasive particles discovered. As shown in fig:3

Formability
The foaming power (flammability) of herbal toothpaste was measured by mixing 2g of toothpaste with 5ml water in a measuring cylinder and shaking it for 10 times. The total volume of foam was calculated. As shown in fig 4.

Determination of moisture and volatile matter
5gm of herbal toothpaste was placed in a porcelain dish with a diameter of 6-8cm and a depth of 2-4cm to determine moisture and volatile matter. At 105 degrees Celsius, it was dried in an oven. As shown in fig:5

Determination of spread ability
Slip and drag characteristics of paste are used to determine the Spread ability technique. About 1-2g of herbal toothpaste was weighed and placed between two glass slides (10 x 10cm) that were stacked one on top of the other (no sliding was allowed), and the slides were moved in opposing directions. After 3 minutes, measure the amount of toothpaste that has spread (in cm). Repeating the experiment and calculating the average of three readings

Result and Discussion
|
Sl.no |
Parameters |
Observation |
|
1 |
Colour |
White |
|
2 |
Odour |
Characteristic |
|
3 |
Taste |
Sweet |
|
4 |
Stability |
Stable |
|
5 |
Spread ability |
Easily spreadable |
|
6 |
Abrasiveness |
Good abrasive |
|
7 |
Foam ability |
Good |
|
SL.no |
Parameters |
Observation |
|
1 |
PH |
10.0 |
|
2 |
Spread ability (cm) |
7.7cm |
|
3 |
Viscosity (CPS) |
39751.7cps |
|
4 |
Tube excludability |
Good |
|
SL.no |
Organisms |
50µg/- Ml |
100µg/- ml |
50µg/- ml |
100µg/- gm |
|
1 |
E.coli |
+ |
+ |
+ |
++ |
|
2 |
S. aureus |
++ |
++ |
++ |
+++ |
|
3 |
klebriella |
+ |
+ |
++ |
++ |
|
4 |
C.albicans |
++ |
++ |
++ |
+++ |
Anti-microbial activity
The disc diffusion method was used to conduct an in-vitro anti-bacterial research of the prepared paste against a pathogenic bacterial strain E. coli utilizing Soybean casein digest medium. When E. coli cells were first grown, they tended to multiply in agar plates. Plates were streaked with inoculum first, then 5mm diameter bores were created into the medium with a sterile cork borer. The agar plate's surface was rotated to provide an even dispersion of inoculums throughout the hole. The prepared paste and commercial formulations were then inserted into the bores of the cultured plates. The plates were wrapped in paraffin, labeled, and incubated for 24 hours at 37 degrees Celsius. After a 24-hour incubation period, each plate was examined.The diameter of zone of inhibition (ZOI) was measured in millimeters (mm) with a ruler. [13], [12], [14] As seen in fig:6,7,8.
Conclusion
The following conclusion can be derived from the findings of this inquiry. This herbal toothpaste plays an important role in maintaining oral hygiene and avoiding dental caries, and it is also safer and has less negative effects than chemically based synthetic toothpaste. All commercially available herbal toothpaste and lab-made versions were assessed and compared to Bureau of Indian Norms standards. Toothpaste that has been specially formulated is capable of maintaining tooth and oral hygiene and has antibacterial activity against microorganisms such as E. coli. In this exploratory in-vitro study, herbal toothpaste was found to be similarly effective as commercially available toothpastes in terms of all toothpaste evaluation parameters. By expanding natural ingredients for making more and safer natural medicines, the designed herbal toothpaste has a bright future in research and dental care for the public, society, and nation. It was determined that the developed herbal toothpaste was of good grade.
Source of Funding
None.
Conflict of Interest
None.
References
- Ersoy M, Tanalp J, Ozel E, Cengizlier R, Soyman M. The allergy of toothpaste: a case report. Allergol Immunopathol. 2008;36(6):368-70. [Google Scholar] [Crossref]
- Davies R, Scully C, Preston AJ. Dentifrices- an update. Medicina Oral Patologia Oral. Cirugia Bucal. 2010;15(6):976-82. [Google Scholar] [Crossref]
- Jardim J, Alves L, Maltz M. The history and global market of oral home-care products. Braz Oral Res. 2009;23:17-22. [Google Scholar] [Crossref]
- Mithal BM, Saha RN. A handbook of cosmetics. . 2000. [Google Scholar]
- Kokate CK, Purohit AP, Gokhale SB. Textbook Of Pharmacognosy. . 2002. [Google Scholar]
- Nema RK, Ks R, Dubey BK. Textbook of Cosmetics. . 2009. [Google Scholar]
- Mangilal T, Ravikumar M. Preparation and Evaluation of Herbal Toothpaste and Compared with Commercial Herbal Toothpastes: An In-vitro Study. Int J Ayurvedic Herbal Med. 2016;5(10):2266-51. [Google Scholar]
- Dange VN, Magdum CS, Mohite SK, Nitlikar M. Review on Oral Care Product: formulation of toothpaste from various and extracts of tender twigs of neem. J of Pharm Res. 2008;1(2):148-52. [Google Scholar]
- Mazumdar M, Makali CM, Patki PS. Evaluation of the Safety and Efficacy of Complete Care Herbal Toothpaste in Controlling Dental Plaque, Gingival Bleeding and Periodontal Diseases. J Homeopathic Ayurvedic Med. 2013;2(2):100-24. [Google Scholar]
- BMM, Saha RN. A Handbook of Csmetics. . 2017. [Google Scholar]
- Mangilal T, Ravikumar M. Preparation and Evaluation of Herbal Toothpaste and Compared with Commercial Herbal Toothpastes: An In-vitro Study. Int J Ayurvedi Herbal Med. 2016;6(3):2266-73. [Google Scholar]
- Mandan SS, Laddha UD, Surana SJ. Experimental Microbiology (Practical).. . 2017. [Google Scholar]
- Lieberman HA, Rieger MM, Banker GS. Pharmaceutical Dosage Forms: Disperse Systems. Informa Healthcare. 2008;2:423-45. [Google Scholar]
- Gaud RS, Gupta G. Practical Microbiology. . 2016. [Google Scholar]
How to Cite This Article
Vancouver
Senthilkumar K, Venkateswaran. S, Vasanthan A, Chiranjeevi P, Mohamed N, Dinesh S, Neshkumar. K. Formulation development and evaluation of novel herbal toothpaste from natural source [Internet]. Int J Pharm Chem Anal. 2022 [cited 2025 Nov 02];9(1):17-21. Available from: https://doi.org/10.18231/j.ijpca.2022.003
APA
Senthilkumar, K., Venkateswaran., S., Vasanthan, A., Chiranjeevi, P., Mohamed, N., Dinesh, S., Neshkumar., K. (2022). Formulation development and evaluation of novel herbal toothpaste from natural source. Int J Pharm Chem Anal, 9(1), 17-21. https://doi.org/10.18231/j.ijpca.2022.003
MLA
Senthilkumar, K.L., Venkateswaran., S., Vasanthan, A., Chiranjeevi, P., Mohamed, N, Dinesh, S., Neshkumar., K.L.S.. "Formulation development and evaluation of novel herbal toothpaste from natural source." Int J Pharm Chem Anal, vol. 9, no. 1, 2022, pp. 17-21. https://doi.org/10.18231/j.ijpca.2022.003
Chicago
Senthilkumar, K., Venkateswaran., S., Vasanthan, A., Chiranjeevi, P., Mohamed, N., Dinesh, S., Neshkumar., K.. "Formulation development and evaluation of novel herbal toothpaste from natural source." Int J Pharm Chem Anal 9, no. 1 (2022): 17-21. https://doi.org/10.18231/j.ijpca.2022.003